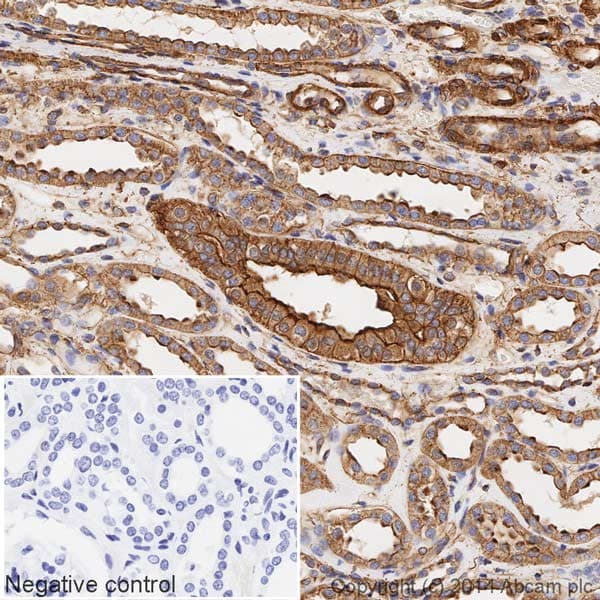
HRP Anti-alpha smooth muscle Actin (acetyl E3) + ACTG2 (acetyl E3) antibody [E184](AB196920)

HRP Anti-alpha smooth muscle Actin (acetyl E3) + ACTG2 (acetyl E3) antibody [E184](AB196920)
$undefined

Rabbit Recombinant Monoclonal alpha smooth muscle Actin acetyl E3 antibody - conjugated to HRP. Suitable for IHC-P, WB and reacts with Human samples.
| Shipped At Conditions | Blue Ice |
| Appropriate Long term Storage Conditions | Store at -20°C. |
| Clonality | Monoclonal |
| Applications | Human |
| Species Reactivity | IHC-P, WB |
| Isotype | IgG |
| Conjugation | HRP |